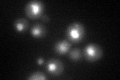
YDR295C
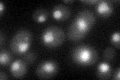
YDR295C
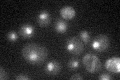
YDR295C

View description
Subunit of a possibly tetrameric trichostatin A-sensitive class II histone deacetylase complex containing an Hda1p homodimer and an Hda2p-Hda3p heterodimer; involved in telomere maintenance
Localization:
Intensity:
Fold change:
Significance:
-
C’ GFP library in SD

nucleus31.17 -
N' NOP1pr-GFP in SD

nucleus34.1739 -
N' TEF2pr-mCherry in SD

nucleus14.4521 -
N' NATIVEpr-GFP in SD

nucleus28.3411 -
N' TEF2pr-VC and Cyto-VN in SD

below threshold26.2512 -
C’ GFP library in SD+DTT
nucleus34.791.11No -
C’ GFP library in SD+H2O2
nucleus33.661.07No -
C’ GFP library in Starvation Media
nucleus27.660.88No -
C’ GFP library on the background of Pup2-DaMP

nucleus -
C’ GFP library on the background of CCT mutant

nucleus28.9790.929549No
